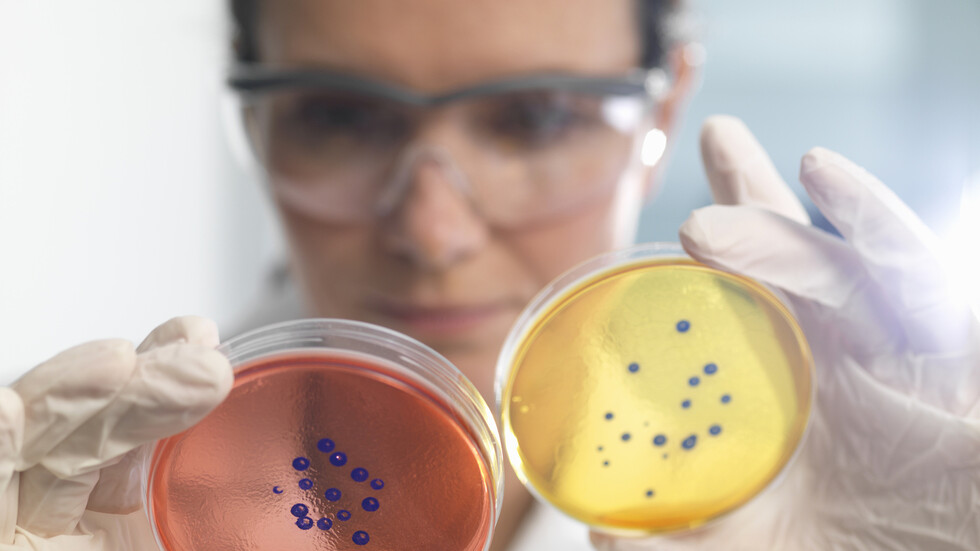
العلماء يكتشفون نشاطا غير متوقع في بكتيريا

Stories
-
نبض الملاعب
RT STORIES
قرار صادم يهدد مستقبل حارس لاتفي سابق شارك في الدوري الروسي
#اسأل_أكثر #Question_MoreRT STORIES
لمسة يد أم لا؟.. رئيس الاتحاد الأوروبي لكرة القدم يشعل الجدل بتصريح صادم
#اسأل_أكثر #Question_MoreRT STORIES
طباخ كريستيانو رونالدو السابق يكشف أسرار لياقته البدنية
#اسأل_أكثر #Question_MoreRT STORIES
كريم بنزيما يثير الجدل مجددا حول علاقته بكريستيانو رونالدو (فيديو)
#اسأل_أكثر #Question_MoreRT STORIES
جدل "وجبة ماكدونالدز" يلاحق إصابة لامين جمال ويشعل النقاش
#اسأل_أكثر #Question_MoreRT STORIES
رسميا.. مدرب يوناني لقيادة المنتخب السعودي خلفا لرينارد (صورة)
#اسأل_أكثر #Question_MoreRT STORIES
"الفيفا" يسقط مقترح ترامب ويضع حدا للتدخلات
#اسأل_أكثر #Question_MoreRT STORIES
بعد محمد صلاح وروبرتسون.. تحديد ثالث الراحلين عن ليفربول
#اسأل_أكثر #Question_MoreRT STORIES
مانشستر سيتي يقترب من الاستقرار على خليفة غوارديولا
#اسأل_أكثر #Question_MoreRT STORIES
صراع السلطة والفساد.. هل تهدد الأزمة حلم الأرجنتين في مونديال 2026؟
#اسأل_أكثر #Question_MoreRT STORIES
موقف إيطالي صارم يعيد الجدل حول معايير المشاركة في مونديال 2026
#اسأل_أكثر #Question_MoreRT STORIES
"يبدو أنني أفعل شيئا مهما".. بطل ملاكمة روسي يسخر من عقوبات أوروبا
#اسأل_أكثر #Question_MoreRT STORIES
رباعة أوكرانية تقاطع روسية على منصة التتويج
#اسأل_أكثر #Question_MoreRT STORIES
شاهد.. حارس مرمى يحرز هدفا "قاتلا" بتسديدة رأسية
#اسأل_أكثر #Question_MoreRT STORIES
جنون الملاعب.. مشجع يخطف الكاميرا خلال بث مباشر لمباراة (فيديو)
#اسأل_أكثر #Question_More
نبض الملاعب
-
العملية العسكرية الروسية في أوكرانيا
RT STORIES
الدفاع الروسية تحصي خسائر قوات كييف خلال أسبوع
#اسأل_أكثر #Question_MoreRT STORIES
ترامب يرد على "نصيحة" الأمير هاري بشأن أوكرانيا ويؤكد مواصلة الجهود الأمريكية لتسوية الصراع
#اسأل_أكثر #Question_MoreRT STORIES
زالوجني: الضربات الروسية على خطوط إمدادنا تجعل من المستحيل شن أي هجوم
#اسأل_أكثر #Question_MoreRT STORIES
مدفيديف: القرض الأوروبي لكييف خديعة جديدة وعبء سداده سيقع على كاهل الشعوب الأوروبية
#اسأل_أكثر #Question_More
العملية العسكرية الروسية في أوكرانيا
-
هدنة بين حزب الله وإسرائيل
RT STORIES
الاتحاد الأوروبي يبحث مع بيروت نشر قوة أوروبية تدعم الجيش اللبناني في نزع سلاح "حزب الله"
#اسأل_أكثر #Question_MoreRT STORIES
غارات إسرائيلية تستهدف عددا من المناطق في جنوب لبنان
#اسأل_أكثر #Question_MoreRT STORIES
الجيش الإسرائيلي يعلن اعتراض صواريخ أطلقت من لبنان
#اسأل_أكثر #Question_MoreRT STORIES
لبنان لحظة بلحظة.. تمديد الهدنة ومفاوضات في البيت الأبيض وسط خروقات ميدانية في الجنوب
#اسأل_أكثر #Question_MoreRT STORIES
ترامب: تمديد وقف إطلاق النار بين إسرائيل ولبنان 3 أسابيع ولإسرائيل الحق في الدفاع عن نفسها
#اسأل_أكثر #Question_MoreRT STORIES
عون يؤكد أنه سيسلك أي طريق لوقف العدوان الإسرائيلي على لبنان ويتحدث عن تقارير "تحدثه مع نتنياهو"
#اسأل_أكثر #Question_More
هدنة بين حزب الله وإسرائيل
-
هدنة وحصار المضيق
RT STORIES
طهران: سنضرب المواقع النفطية في الدول التي ينطلق منها أي عدوان علينا وردنا سيتجاوز مبدأ العين بالعين
#اسأل_أكثر #Question_MoreRT STORIES
إيران لحظة بلحظة.. هدنة مستمرة وترامب يهدد بنفاد الوقت أمام طهران من أجل التفاوض
#اسأل_أكثر #Question_MoreRT STORIES
ترامب: بحرية إيران لم يتبق منها سوى زوارق صغيرة وسندمرها والجيش الإيراني هزم تماما
#اسأل_أكثر #Question_MoreRT STORIES
خطط أمريكية لضرب دفاعات إيران في مضيق هرمز إذا انهار وقف إطلاق النار
#اسأل_أكثر #Question_MoreRT STORIES
شبكة CNN: إيران تمسك بزمام حرب الاستنزاف مع الولايات المتحدة
#اسأل_أكثر #Question_MoreRT STORIES
الدفاعات الجوية في طهران تتصدى لهدف معاد وسماع دوي إطلاق نار غربا وشرقا
#اسأل_أكثر #Question_More
هدنة وحصار المضيق
-
فيديوهات
RT STORIES
الجيش الإسرائيلي يعلن العثور على مقر قيادة لـ"حزب الله" داخل محل ملابس
#اسأل_أكثر #Question_MoreRT STORIES
ومضات ضوئية في سماء طهران خلال مسيرة وسط أنباء عن "تفعيل الدفاعات الجوية" في العاصمة الإيرانية
#اسأل_أكثر #Question_MoreRT STORIES
قيمتها 600 ألف يورو.. الجيش الإسباني يدمر مركبة مدرعة في أثناء عملية إنزال جوي
#اسأل_أكثر #Question_MoreRT STORIES
صحافيون لبنانيون يحتجون في بيروت بعد مقتل زميلتهم آمال خليل بغارة إسرائيلية
#اسأل_أكثر #Question_MoreRT STORIES
الحرس الثوري يطلي صاروخا باللون الأزرق تلبية لطلب طفل إيراني
#اسأل_أكثر #Question_MoreRT STORIES
نشاط أمني للشرطة الإسرائيلية في حي مئة شعاريم بالقدس وإزالة أعلام فلسطينية
#اسأل_أكثر #Question_MoreRT STORIES
تشييع جثمان الصحفية اللبنانية آمال خليل في بلدة البيسرية
#اسأل_أكثر #Question_More
فيديوهات
بعد 200 عام من الغموض.. علماء يحلون أحد أبرز ألغاز الكيمياء الفيزيائية
لم يتمكن العلماء من تفسير الطريقة التي تتحرك بها البروتونات عبر الماء بشكل دقيق ومقنع منذ 200 عام، عندما اقترح ثيودور غروتوس نظرية في شأنها.
ومع ذلك، نجحت نتائج دراسة حديثة أجراها فريق دولي من الأكاديميين في إظهار نظرية تجيب عن هذا السؤال، وفقا لجامعة بن غوريون في إسرائيل.
How does a proton move through water? 💧 Many researchers attempted to update the Grotthuss Mechanism.
— European Research Council (ERC) (@ERC_Research) October 1, 2022
Now, ERC grantee Erik Nibbering @FVB_adlershof replicated a model proposed by Ehud Pines while being X-rayed to reveal the solution. @physorg_com: https://t.co/nUljFpMbJ1 pic.twitter.com/PiniI7WLMu
وفي عام 1806، طرح ثيودور غروتوس فرضية، عُرفت باسم آلية غروتوس "لقفز البروتون"، حول كيفية تدفق الشحنة عبر محلول الماء، وهي قيام بروتون زائد بالتأثير على شبكة الروابط الهيدروجينية لجزيئات الماء أو السوائل الأخرى ذات الروابط الهيدروجينية من خلال انقسام أو تشكيل روابط تساهمية.
Ehud Pines and his proton transfer mechanism!!! Amazing stuff! Perseverance over the years! Grotthus substituted by the "Pines Mechanism"
— Jyotishman Dasgupta (@jd1278) October 1, 2022
The Paper by Nibbering:https://t.co/S76xxl1Kem
Commentary for Pines here:https://t.co/LB10BWP9BQ
وفي حين أن فرضية غروتوس كانت تفكيرا تقدميا للغاية حينذاك، قبل أن تكون البروتونات، أو حتى البنية الفعلية للماء معروفة، فإن العلماء المعاصرين عرفوا منذ فترة طويلة أنها لم تقدم فهما كاملا لما يحدث على المستوى الجزيئي.
وربما تكون أحدث النتائج حول هذا الموضوع اكتشاف اللغز من خلال حل الهياكل الإلكترونية للبروتونات الرطبة التي ظلت بعيدة المنال لفترة طويلة.

علماء: الانعكاسات المنبعثة من القطب الجنوبي للمريخ قد تكون ناجمة عن شيء أغرب من الماء!
وأجرى العلماء تجربة امتصاص الأشعة السينية لقياس تأثير شحنة البروتون على التركيب الإلكتروني الداخلي لذرات الأكسجين في الماء، مؤكدين أن البروتونات تتحرك عبر الماء في "قطارات (سلاسل) من الماء ثلاثية الجزيئات"، على النحو الذي اقترحه إيهود باينز، الكيميائي في جامعة بن غوريون في النقب في إسرائيل.
وأظهرت النتائج أن وجود بروتون يفسد ثلاثة جزيئات ماء، مكونا "سلاسل أو قطارات" من جزيئات الماء "البروتونية".
ويوضح الفريق: "يبني قطار الجزيئات المسارات الموجودة أسفله لتحريكها، ثم يفكك المسارات ويعيد بناءها أمامه لمواصلة المضي قدما. إنها حلقة من المسارات التي تختفي وتعاود الظهور وتستمر بلا نهاية".
وتابع باينز: "اشتعلت المناقشات حول آلية غروتوس وطبيعة ذوبان البروتون في الماء، لأن هذا أحد أهم التحديات الأساسية في الكيمياء. وفهم هذه الآلية هو علم خالص يدفع بحدود معرفتنا ويغير أحد مفاهيمنا الأساسية لإحدى آليات نقل الكتلة والشحنة في الطبيعة".
وتبدو نتائج الدراسة الجديدة مقنعة لأنها تجمع بين النهج النظري والتجريب الفيزيائي، الذي أصبح ممكنا بفضل التطورات التكنولوجية الحديثة.
وقد استخدم العلماء تجربة التحليل الطيفي لامتصاص الأشعة السينية (XAS) لمراقبة كيفية تأثير شحنات البروتون على الإلكترونات في ذرات الأكسجين المفردة في الماء.
وكما هو متوقع، كان التأثير أكبر على ثلاثة جزيئات ماء، على الرغم من النطاقات المختلفة على كل جزيء فردي داخل الكتلة الثلاثية.
العلماء يكتشفون نشاطا غير متوقع في بكتيريا "ميتة"
ووجد الفريق مجموعات من ثلاث جزيئات تشكل سلاسل مع البروتون. ودمج العلماء أيضا عمليات المحاكاة والحسابات الكيميائية على مستوى الكم لتحديد التفاعل في ما بين البروتونات وجزيئات الماء المجاورة أثناء تحرك البروتونات عبر السائل.
ويقول باينز: "إن فهم هذه الآلية هو علم خالص، يدفع بحدود معرفتنا ويغير أحد مفاهيمنا الأساسية لواحدة من أهم آليات النقل الجماعي والشحن في الطبيعة".
ويلعب هذا الاكتشاف دورا في العديد من العمليات الكيميائية الأخرى، بما في ذلك التمثيل الضوئي وتنفس الخلايا ونقل الطاقة في خلايا وقود الهيدروجين.
وأضاف باينز: "فكر الجميع في هذه المشكلة لأكثر من 200 عام، لذلك كان ذلك بمثابة تحد كاف لي كي أقرر البحث فيها. وبعد سبعة عشر عاما، أنا ممتنٍ لأنني على الأرجح وجدت الحل وها أنا أظهره".
نُشرت نتائج الدراسة مفصلة في مجلة Angewandte Chemie International Edition.
المصدر: ساينس ألرت
التعليقات